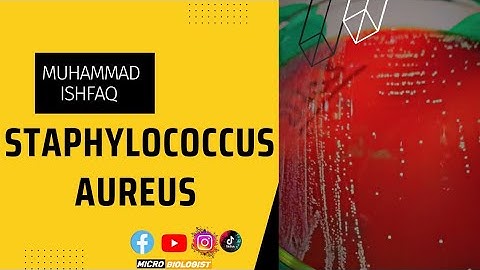
Understanding Staphylococcus aureus Symptoms Treatment and Prevention || #microbiologist

⬇ DOWNLOAD NOW
Kalau muncul iklan pop-up, tutup lalu klik tombol kembali
Download lagu Treatment and Prevention of Staphylococcus Aureus part2 secara gratis hanya untuk keperluan promosi. Dukung artis favorit kamu dengan membeli musik original di iTunes atau platform resmi lainnya.
 Ask a Doctor: Staph Infection
Ask a Doctor: Staph Infection
 Staphylococcus aureus Causes, Symptoms, identification, Treatment, and Prevention (English)
Staphylococcus aureus Causes, Symptoms, identification, Treatment, and Prevention (English)
 staphylococcus aureus part 2
staphylococcus aureus part 2
 Staphylococcus Aureus Symptoms Treatment And Prevention
Staphylococcus Aureus Symptoms Treatment And Prevention
 Staphylococcus aureus
Staphylococcus aureus
Understanding Staphylococcus aureus Symptoms Treatment and Prevention || #microbiologist
Understanding Staphylococcus aureus Symptoms Treatment and Prevention || #microbiologist
 Methicillin-Resistant Staphylococcus aureus (MRSA)
Methicillin-Resistant Staphylococcus aureus (MRSA)
 Staphylococcus aureus Sepsis: Crucial Tips for Clinicians
Staphylococcus aureus Sepsis: Crucial Tips for Clinicians